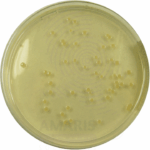
Nutrient Agar Amaris Chemicals

Methylene Glycol
Methylene Glycol is a chemical compound formed by the reversible reaction of formaldehyde with water. It exists in equilibrium with formaldehyde in aqueous solutions and is commonly used as a disinfectant, preservative, and industrial biocide. Due to its antimicrobial properties, it is widely applied in water treatment, cosmetics, and embalming fluids.
Methylene Glycol
Primary Uses
- Disinfection & Sanitization
- Used in water treatment systems to control microbial growth.
- Effective in disinfecting medical equipment and surfaces.
- Applied in cooling tower treatments to prevent biofouling.
- Preservation
- Acts as a preservative in cosmetics and personal care products.
- Extends shelf life of industrial fluids (e.g., metalworking fluids).
- Used in embalming fluids for tissue fixation.
- Industrial Biocide
- Prevents bacterial and fungal growth in paper/pulp manufacturing.
- Used in oilfield operations to inhibit microbial contamination.
- Treats wastewater to reduce organic load and pathogens.
Secondary Uses
- Textile Industry
- Prevents mildew in fabrics during storage and shipping.
- Used in dye fixation processes.
- Laboratory Applications
- Acts as a fixative in histology and pathology samples.
- Used in formaldehyde-releasing reagent formulations.
- Agriculture
- Seed treatment to prevent fungal infections.
- Soil sterilization in greenhouse cultivation.
1. Basic Identification Attributes
- Chemical Name (IUPAC): Methanediol
- Common/Trade Name: Methylene Glycol
- CAS Number: 463-57-0
- HS Code: 2912.11.00 (Formaldehyde derivatives)
- Synonyms: Formaldehyde hydrate; Formalin (aqueous solution)
2. Physical & Chemical Properties
- Physical State: Liquid (in aqueous solution)
- Color & Odor: Colorless; pungent formaldehyde-like odor
- pH: ~3.5–5.5 (in solution)
- Solubility: Fully miscible with water
- Density: ~1.08–1.09 g/cm³ (37% solution)
3. Safety & Hazard Attributes
- GHS Classification:
- H301 (Toxic if swallowed)
- H311 (Toxic in contact with skin)
- H314 (Causes severe skin burns and eye damage)
- H317 (May cause allergic skin reaction)
- H331 (Toxic if inhaled)
- H341 (Suspected of causing genetic defects)
- H350 (May cause cancer)
- Toxicity: Highly toxic; carcinogenic and mutagenic potential
- Exposure Limits:
- OSHA PEL (Formaldehyde): 0.75 ppm (TWA)
- ACGIH TLV: 0.3 ppm (Ceiling)
4. Storage & Handling Attributes
- Storage Conditions:
- Store in sealed, corrosion-resistant containers.
- Keep in a cool, ventilated area away from heat/oxidizers.
- Container Type: Polyethylene or stainless-steel containers.
- Shelf Life: 6–12 months (stabilized solutions).
- Handling Precautions:
- Use PPE (gloves, goggles, respirator).
- Avoid inhalation or skin contact.
5. Regulatory & Compliance Attributes
- Complies with:
- EPA FIFRA (biocidal applications).
- EU REACH (restricted under Annex XVII).
- FDA (limited use in cosmetics).
- Restrictions: Banned in consumer products in some regions (e.g., EU cosmetics).
6. Environmental & Health Impact
- Biodegradability: Readily biodegradable (forms formaldehyde).
- Ecotoxicity: Toxic to aquatic life (LC50 < 10 mg/L).
- Bioaccumulation: Low potential.
- Carcinogenicity/Mutagenicity:
- IARC Group 1 (Formaldehyde: carcinogenic to humans).
Safety Handling Precautions
- PPE Required:
- Nitrile/neoprene gloves, chemical goggles, respirator (organic vapor cartridge).
- Handling Guidelines:
- Use in fume hoods or well-ventilated areas.
- Prohibit eating/drinking near handling areas.
- Storage Measures:
- Separate from amines, strong acids, and oxidizers.
First Aid Measures
- Inhalation: Move to fresh air; seek medical attention.
- Skin Contact: Rinse immediately with water; remove contaminated clothing.
- Eye Contact: Flush with water for 15 mins; seek emergency care.
- Ingestion: Do NOT induce vomiting; rinse mouth; call poison control.
Firefighting Measures
- Fire Hazards: Combustible at high temperatures.
- Extinguishing Media: Water spray, CO₂, dry chemical.
- Special Precautions: Wear self-contained breathing apparatus (SCBA).
- Hazardous Combustion Products: Formaldehyde, CO, CO₂.
Related products
Apricot Powder
Apricot powder is a dehydrated, finely ground form of apricot fruit, retaining much of the natural flavor, aroma, and nutritional properties of fresh apricots. It is typically made by drying fresh apricots through spray drying, freeze drying, or drum drying, then milling into a fine powder. Apricot powder is rich in vitamins, minerals, dietary fiber, and antioxidants such as beta-carotene and vitamin C. It is widely used as a natural flavoring agent, colorant, and nutritional supplement in food and beverage products, as well as in cosmetics and dietary supplements. Its convenient powdered form allows for easy incorporation into dry mixes and processed goods without the perishability of fresh fruit.
Beta Carotene
Beta Carotene is a concentrated formulation of beta carotene, a naturally occurring red-orange pigment found in plants and fruits. It is a precursor to vitamin A and a potent antioxidant that helps protect cells from oxidative damage. This product, typically suspended in an oil base or suitable carrier, is widely used as a natural colorant, nutritional supplement, and cosmetic ingredient. Beta Carotene 30% SUN offers enhanced stability under sunlight exposure, making it ideal for food, feed, and cosmetic applications where light stability is critical.
Ferulic Acid
Ferulic Acid is a naturally occurring hydroxycinnamic acid classified as a phenolic compound with potent antioxidant properties. It exists as a pale yellow to light brown crystalline powder with a faint characteristic odor. Ferulic Acid is commonly found in the cell walls of various plants such as rice bran, wheat, oats, coffee, apples, and fruits, where it plays a role in plant structural integrity and defense against environmental stress. It is valued across multiple industries—cosmetics, pharmaceuticals, nutraceuticals, food, and agriculture—due to its ability to neutralize free radicals, absorb UV radiation, and exhibit anti-inflammatory and antimicrobial activities.
Fish Collagen
Fish Collagen is a natural protein derived from the skin, scales, and bones of various fish species through enzymatic hydrolysis or acid extraction. It is predominantly Type I collagen, known for its excellent bioavailability and biocompatibility. Fish Collagen typically appears as a fine white to off-white powder with low odor and high solubility in water and acidic solutions. It is widely prized in cosmetics, nutraceuticals, pharmaceuticals, and food industries due to its superior absorption compared to mammalian collagen, making it highly effective in skin, joint, and bone health applications. Fish Collagen supports the body’s extracellular matrix, promoting skin elasticity, hydration, and tissue repair.
Guanidine Carbonate
Guanidine Carbonate is a white crystalline powder, highly soluble in water, with strong basicity and high nitrogen content. It’s a versatile chemical intermediate widely used in pharmaceuticals, agriculture, polymer chemistry, textiles, and laboratory research. Its buffering properties and reactivity make it valuable in synthesis, pH regulation, and as a nitrogen source.
Kojic Acid
Kojic Acid is a naturally derived organic compound produced by certain species of fungi, commonly Aspergillus and Penicillium. It appears as a white to light yellow crystalline powder with a slightly acidic taste and is highly soluble in water and alcohol. Kojic Acid is primarily used in the cosmetic and pharmaceutical industries for its skin-lightening and antioxidant properties. It inhibits melanin production by blocking the enzyme tyrosinase, making it a key ingredient in formulations aimed at reducing hyperpigmentation, age spots, and uneven skin tone.
Methoxy benzophenone Sulfonic Acid
Methoxy Benzophenone Sulfonic Acid is a water-soluble UV filter widely used in sunscreen and cosmetic formulations. It absorbs ultraviolet (UV) radiation, primarily in the UVB range, protecting skin and products from harmful effects of sun exposure. This compound appears as a white to off-white powder or crystalline solid and is valued for its photostability and broad-spectrum UV protection.
Silk Proteins
Silk Proteins are hydrolyzed proteins derived from natural silk fibers, typically composed of fibroin and sericin. They are water-soluble, bioactive compounds known for their excellent film-forming, moisture-retaining, and conditioning properties. Silk proteins are widely used in cosmetics, personal care products, pharmaceuticals, and textiles due to their biocompatibility, smooth texture, and ability to penetrate and protect surfaces like skin, hair, and fabric.


 Preservatives(food)
Preservatives(food) Flavor Enhancers
Flavor Enhancers Acidulants
Acidulants Sweeteners
Sweeteners Antioxidants
Antioxidants Colorants(food)
Colorants(food) Nutraceutical Ingredients (food)
Nutraceutical Ingredients (food) Nutrient Supplements
Nutrient Supplements Emulsifiers
Emulsifiers
 Collectors
Collectors Dust Suppressants
Dust Suppressants Explosives and Blasting Agents
Explosives and Blasting Agents Flocculants and Coagulants
Flocculants and Coagulants Frothers
Frothers Leaching Agents
Leaching Agents pH Modifiers
pH Modifiers Precious Metal Extraction Agents
Precious Metal Extraction Agents
 Antioxidants(plastic)
Antioxidants(plastic) Colorants (Pigments, Dyes)
Colorants (Pigments, Dyes) Fillers and Reinforcements
Fillers and Reinforcements Flame Retardants
Flame Retardants Monomers
Monomers Plasticizers
Plasticizers Polymerization Initiators
Polymerization Initiators Stabilizers (UV, Heat)
Stabilizers (UV, Heat)
 Antifoaming Agents
Antifoaming Agents Chelating Agents
Chelating Agents Coagulants and Flocculants
Coagulants and Flocculants Corrosion Inhibitors
Corrosion Inhibitors Disinfectants and Biocides
Disinfectants and Biocides Oxidizing Agents
Oxidizing Agents pH Adjusters
pH Adjusters Scale Inhibitors( water)
Scale Inhibitors( water)
 Antioxidants(cosmetic)
Antioxidants(cosmetic) Emollients
Emollients Fragrances and Essential Oils
Fragrances and Essential Oils Humectants
Humectants Preservatives
Preservatives Surfactants(cosmetic)
Surfactants(cosmetic) Thickeners
Thickeners UV Filters
UV Filters
 Fertilizers
Fertilizers Soil Conditioners
Soil Conditioners Plant Growth Regulators
Plant Growth Regulators Animal Feed Additives
Animal Feed Additives Biostimulants
Biostimulants Pesticides (Herbicides, Insecticides, Fungicides)
Pesticides (Herbicides, Insecticides, Fungicides)
 Active Pharmaceutical Ingredients (APIs)
Active Pharmaceutical Ingredients (APIs) Excipients
Excipients Solvents(pharmaceutical)
Solvents(pharmaceutical) Antibiotics
Antibiotics Antiseptics and Disinfectants
Antiseptics and Disinfectants Vaccine Adjuvants
Vaccine Adjuvants Nutraceutical Ingredients (pharmaceutical)
Nutraceutical Ingredients (pharmaceutical) Analgesics & Antipyretics
Analgesics & Antipyretics
 Analytical Reagents
Analytical Reagents Solvents(lab)
Solvents(lab) Chromatography Chemicals
Chromatography Chemicals Spectroscopy Reagents
Spectroscopy Reagents microbiology-and-cell-culture-reagents
microbiology-and-cell-culture-reagents Molecular Biology Reagents
Molecular Biology Reagents Biochemical Reagents
Biochemical Reagents Inorganic and Organic Standards
Inorganic and Organic Standards Laboratory Safety Chemicals
Laboratory Safety Chemicals Specialty Laboratory Chemicals(Special Laboratory Equipment)
Specialty Laboratory Chemicals(Special Laboratory Equipment)
 Demulsifiers
Demulsifiers Hydraulic Fracturing Fluids
Hydraulic Fracturing Fluids Scale Inhibitors(oil)
Scale Inhibitors(oil) Surfactants(oil)
Surfactants(oil) Drilling Fluids
Drilling Fluids
 Dyes and Pigments
Dyes and Pigments Bleaching Agents
Bleaching Agents Softening Agents
Softening Agents Finishing Agents
Finishing Agents Antistatic Agents
Antistatic Agents
 Admixtures
Admixtures Waterproofing Agents
Waterproofing Agents Sealants and Adhesives
Sealants and Adhesives Curing Compounds
Curing Compounds Concrete Repair Chemicals
Concrete Repair Chemicals Anti-Corrosion Coatings
Anti-Corrosion Coatings
 Surfactants(cleaning)
Surfactants(cleaning) Builders
Builders Enzymes
Enzymes Solvents (Cleaning)
Solvents (Cleaning) Fragrances
Fragrances
 Electronic Chemicals
Electronic Chemicals Catalysts
Catalysts Lubricants
Lubricants Photographic Chemicals
Photographic Chemicals Refrigerants
Refrigerants Automotive chemicals
Automotive chemicals Pyrotechnic Chemicals
Pyrotechnic Chemicals
 Biodegradable Surfactants
Biodegradable Surfactants Bio-based Solvents
Bio-based Solvents Renewable Polymers
Renewable Polymers Carbon Capture Chemicals
Carbon Capture Chemicals Wastewater Treatment Chemicals
Wastewater Treatment Chemicals
 Pigments
Pigments Solvents(paint)
Solvents(paint) Specialty Coatings
Specialty Coatings Binders/Resins
Binders/Resins Additives
Additives Driers
Driers Anti-Corrosion Agents
Anti-Corrosion Agents Functional Coatings
Functional Coatings Application-Specific Coatings
Application-Specific Coatings
 Leavening Agents
Leavening Agents Dough Conditioners
Dough Conditioners Flour Treatments
Flour Treatments Fat Replacers
Fat Replacers Decoratives
Decoratives Preservatives(baking)
Preservatives(baking)
 Plasticizers & Softeners
Plasticizers & Softeners Reinforcing Agents
Reinforcing Agents Adhesion Promoters
Adhesion Promoters Vulcanizing Agents
Vulcanizing Agents Antidegradants
Antidegradants Blowing Agents
Blowing Agents Fillers & Extenders
Fillers & Extenders Accelerators & Retarders
Accelerators & Retarders